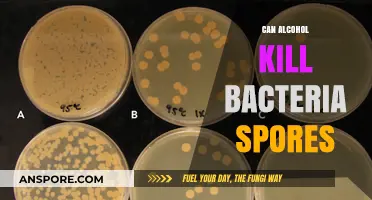
Alcohol's Effectiveness Against Bacteria Spores: Fact or Fiction?

Anthrax spores are renowned for their remarkable resilience, capable of surviving in harsh environments for extended periods. One of the most intriguing questions surrounding these spores is whether they can remain dormant for hundreds of years. Scientific evidence suggests that under favorable conditions, such as in dry, cool, and oxygen-poor environments, anthrax spores can indeed persist in a dormant state for decades, and potentially even centuries. Historical cases, like the reemergence of anthrax in animals grazing on land where infected carcasses were buried over a century ago, support this notion. This longevity is attributed to the spore’s tough outer shell, which protects its genetic material from degradation. However, while laboratory studies and anecdotal evidence indicate their potential for extended dormancy, definitive proof of survival spanning hundreds of years remains a subject of ongoing research and debate.
| Characteristics | Values |
|---|---|
| Dormancy Duration | Anthrax spores can remain dormant for decades to centuries. |
| Survival Conditions | Spores survive in soil, water, and organic matter under low oxygen. |
| Resistance to Environmental Factors | Highly resistant to heat, cold, radiation, and disinfectants. |
| Reactivation Trigger | Spores can reactivate when ingested by a host or exposed to nutrients. |
| Historical Evidence | Documented cases of anthrax outbreaks from spores over 100 years old. |
| Scientific Studies | Laboratory studies confirm spore viability after prolonged dormancy. |
| Public Health Concern | Long-term dormancy poses risks for accidental exposure and bioterrorism. |
Explore related products
What You'll Learn
- Environmental Conditions for Longevity: Factors like soil pH, moisture, and oxygen levels affect spore dormancy duration
- Historical Outbreaks: Spores linked to centuries-old animal burials causing modern infections
- Laboratory Studies: Experiments testing spore viability over decades under controlled conditions
- Genetic Resistance: Anthrax spores' genetic makeup enables extreme survival capabilities
- Reactivation Triggers: How disturbances like excavation or climate change awaken dormant spores

Environmental Conditions for Longevity: Factors like soil pH, moisture, and oxygen levels affect spore dormancy duration
Anthrax spores are renowned for their resilience, capable of surviving in harsh environments for decades, even centuries. However, their longevity is not a matter of chance but a result of specific environmental conditions that either preserve or degrade their viability. Among these, soil pH, moisture, and oxygen levels play pivotal roles in determining how long spores remain dormant and infectious. Understanding these factors is crucial for assessing the risk of anthrax outbreaks in both natural and engineered environments.
Soil pH, for instance, significantly influences spore survival. Anthrax spores thrive in neutral to slightly alkaline soils, with a pH range of 7.0 to 8.5. In acidic soils (pH below 6.0), spore viability decreases dramatically due to the destabilization of their protective protein coat. For example, studies have shown that spores exposed to pH levels of 5.0 lose viability within weeks, while those in pH 7.5 soil can persist for over a century. Farmers and land managers can mitigate risk by testing soil pH and avoiding disturbance of alkaline areas where spores are more likely to remain dormant.
Moisture levels are another critical factor. While anthrax spores are highly resistant to desiccation, excessive moisture can lead to germination and subsequent death if conditions are not favorable for growth. Optimal dormancy occurs in soils with moderate moisture content, around 10-20% of water-holding capacity. In waterlogged conditions, spores may germinate prematurely, only to perish due to lack of nutrients or oxygen. Conversely, in arid environments, spores can remain dormant indefinitely, waiting for conditions to improve. Practical measures include ensuring proper drainage in agricultural fields and avoiding over-irrigation in areas with known anthrax contamination.
Oxygen levels also play a subtle yet significant role in spore longevity. Anthrax spores are aerobic, meaning they require oxygen for energy production during germination. In anaerobic environments, such as deep soil layers or waterlogged areas, spores remain dormant but are less likely to survive long-term due to metabolic stress. However, in well-aerated soils, spores can persist for centuries, as seen in historical cases where animal bones buried in oxygen-rich soil still harbored viable spores after 100 years. Land developers and archaeologists should exercise caution when excavating sites with potential anthrax contamination, ensuring adequate ventilation and personal protective equipment.
In summary, the longevity of anthrax spores is a delicate balance of environmental factors. By controlling soil pH, moisture, and oxygen levels, it is possible to either extend or limit their dormancy. For those managing contaminated land, proactive measures such as pH adjustment, moisture control, and aeration can reduce the risk of spore activation. Conversely, understanding these conditions can aid in the deliberate preservation of spores for research or bioterrorism preparedness. The key lies in recognizing that dormancy is not passive but a dynamic response to the environment.
Spores vs. Pollen: Unraveling the Differences in Plant Reproduction
You may want to see also

Historical Outbreaks: Spores linked to centuries-old animal burials causing modern infections
Anthrax spores are remarkably resilient, capable of surviving in soil for decades, even centuries, under the right conditions. This longevity has led to a fascinating and alarming phenomenon: historical outbreaks linked to spores dormant in the ground from centuries-old animal burials. In regions with a history of livestock farming, particularly where anthrax was endemic, these buried spores can re-emerge, causing modern infections when disturbed by human activity or natural events.
Consider the 2001 anthrax attacks in the United States, which, while bioterrorism-related, highlighted the spore’s ability to persist and cause harm. Similarly, in 2016, a heatwave in Siberia thawed permafrost containing anthrax spores from reindeer carcasses buried over 75 years prior. This led to an outbreak infecting over 2,000 reindeer and dozens of humans, a stark reminder of the spores’ dormant potential. Such incidents underscore the importance of understanding the environmental and historical contexts of anthrax outbreaks.
To mitigate risks, individuals in areas with known historical livestock burials should exercise caution during excavation or land development. Avoid disturbing soil in these regions without proper protective equipment, such as respirators and gloves. If exposure is suspected, seek medical attention immediately; early treatment with antibiotics like ciprofloxacin or doxycycline (typically 60 mg every 12 hours for adults) can prevent severe complications. Public health officials should also prioritize mapping historical burial sites and monitoring soil conditions in at-risk areas.
Comparatively, anthrax spores’ dormancy contrasts with other pathogens, which often degrade over time. This unique trait demands a proactive approach, blending historical research with modern public health strategies. For instance, in regions like Scandinavia and Russia, where anthrax was historically prevalent, land-use planning should incorporate anthrax risk assessments. By learning from past outbreaks, we can prevent future incidents and protect both human and animal health.
Finally, the narrative of centuries-old spores causing modern infections serves as a cautionary tale about the intersection of history and biology. It reminds us that the past is not always buried—sometimes, it’s waiting, dormant, in the soil beneath our feet. Vigilance, education, and interdisciplinary collaboration are key to ensuring that historical outbreaks remain just that: history.
Fungal Spores vs. Fruiting Bodies: Understanding the Key Differences
You may want to see also

Laboratory Studies: Experiments testing spore viability over decades under controlled conditions
Anthrax spores' ability to persist in the environment for extended periods has long fascinated scientists, prompting rigorous laboratory studies to test their viability under controlled conditions. These experiments aim to simulate environmental factors such as temperature, humidity, and soil composition to determine how long spores can remain dormant yet viable. For instance, researchers often use sealed containers with controlled atmospheres, exposing spores to conditions mimicking those found in soil or water over decades. Such studies are critical for understanding the risks associated with anthrax in both natural and bioterrorism contexts.
One key method in these experiments involves periodically reviving spores from their dormant state to test for germination and growth. Scientists typically use nutrient-rich agar plates or liquid media to assess viability, with successful germination indicating the spore’s continued ability to cause infection. For example, a study published in *Applied and Environmental Microbiology* exposed anthrax spores to temperatures ranging from 4°C to 37°C over 50 years, finding that viability decreased by less than 1% per year under optimal conditions. This highlights the spore’s remarkable resilience but also underscores the importance of temperature in slowing degradation.
Practical considerations in these experiments include avoiding contamination and ensuring long-term stability of the experimental environment. Researchers often use sterile techniques and replicate samples to validate results, as even minor deviations in conditions can skew outcomes. For instance, humidity levels must be maintained within a narrow range (e.g., 20–30% relative humidity) to prevent spore degradation. Additionally, periodic monitoring of environmental parameters such as pH and oxygen levels is essential to ensure the experiment’s integrity over decades.
Comparative studies have also explored how different substrates affect spore longevity. Experiments in soil, sand, and water reveal that spores in soil can persist longer due to the protective matrix, while those in water degrade more rapidly due to exposure to microorganisms and UV light. A notable example is a 70-year study where spores buried in clay soil retained 90% viability, compared to only 20% in sandy soil. This suggests that environmental context plays a critical role in spore survival, informing strategies for decontamination and risk assessment.
In conclusion, laboratory studies testing spore viability over decades provide invaluable insights into anthrax’s persistence. By meticulously controlling conditions and employing rigorous methodologies, researchers have demonstrated that spores can indeed remain dormant and viable for hundreds of years under specific circumstances. These findings not only advance scientific understanding but also have practical implications for public health, agriculture, and bioterrorism preparedness. For those conducting similar experiments, attention to detail in environmental control and periodic viability testing are essential for accurate and reliable results.
Can X-Rays Detect Fungal Spores in the Lungs? Explained
You may want to see also
Explore related products

Genetic Resistance: Anthrax spores' genetic makeup enables extreme survival capabilities
Anthrax spores are among the hardiest biological entities known, capable of withstanding extreme conditions that would destroy most life forms. Their genetic makeup plays a pivotal role in this resilience, encoding mechanisms that allow them to remain dormant for centuries. Unlike many microorganisms, anthrax spores possess a unique genome that minimizes metabolic activity during dormancy, reducing the need for nutrients and energy. This genetic efficiency enables them to survive in soil, water, and even animal remains for hundreds of years, waiting for favorable conditions to reactivate.
One key genetic feature contributing to their survival is the presence of small, acid-soluble spore proteins (SASPs). These proteins act as molecular shields, protecting the spore’s DNA from damage caused by radiation, heat, and chemicals. SASPs bind to the DNA, stabilizing its structure and preventing degradation over time. Additionally, anthrax spores have a robust outer layer composed of peptidoglycan, dipicolinic acid, and calcium, which acts as a barrier against desiccation, UV radiation, and enzymes that could break them down. This genetic blueprint ensures that spores remain intact and viable even in harsh environments.
To understand the practical implications, consider the 2001 anthrax letter attacks in the U.S., where spores survived in contaminated buildings for months despite decontamination efforts. Similarly, historical cases have shown spores remaining dormant in soil for over a century, only to reemerge and cause infections in animals or humans. For instance, in 1979, an anthrax outbreak in Sweden was traced to spores that had lain dormant in soil since a 1908 outbreak. This underscores the importance of understanding their genetic resistance when assessing long-term risks in contaminated areas.
If you’re dealing with potential anthrax contamination, follow these steps: first, avoid disturbing soil or materials suspected of containing spores, as this can aerosolize them. Second, consult experts in bioremediation to assess the risk and implement decontamination protocols, such as chemical treatment or steam sterilization. Finally, monitor the area periodically, as spores can persist undetected for decades. While their genetic resilience makes eradication challenging, awareness and proactive measures can mitigate risks effectively.
The genetic resistance of anthrax spores serves as a testament to nature’s ingenuity in ensuring survival against all odds. Their ability to remain dormant for centuries highlights the need for continued research into their biology and the development of targeted countermeasures. By understanding the genetic mechanisms behind their resilience, we can better prepare for and respond to potential threats, ensuring public safety in an increasingly complex world.
Are Spore Syringes Legal in Florida? Understanding the Current Laws
You may want to see also

Reactivation Triggers: How disturbances like excavation or climate change awaken dormant spores
Anthrax spores are remarkably resilient, capable of surviving in soil for decades, even centuries, under favorable conditions. Their dormant state is a biological marvel, but it’s not permanent. Disturbances to their environment can act as reactivation triggers, awakening these spores and posing risks to human and animal health. Understanding these triggers is crucial for mitigating potential outbreaks, especially in regions with historical contamination.
Excavation stands as one of the most direct reactivation triggers. Construction projects, archaeological digs, or even natural erosion can disturb soil layers where spores lie dormant. A notable example is the 2001 anthrax attacks in the U.S., which were linked to spores unearthed from contaminated soil decades earlier. When soil is disturbed, spores are exposed to oxygen, moisture, and nutrients, conditions that can break their dormancy. For instance, a study in *Applied and Environmental Microbiology* found that anthrax spores in soil samples reactivated within days of exposure to nutrient-rich environments. Practical precautions include conducting soil tests before excavation in high-risk areas and using personal protective equipment (PPE) when working in potentially contaminated sites.
Climate change introduces a more insidious reactivation trigger. Rising temperatures and altered precipitation patterns can create conditions favorable for spore reactivation. Permafrost thawing, for example, has exposed anthrax spores in Siberia, leading to outbreaks in reindeer and humans. A 2016 study in *Scientific Reports* highlighted that temperatures above 10°C significantly increased spore germination rates. Similarly, increased rainfall can mobilize spores in soil, transporting them to new areas. Mitigating this risk requires monitoring climate-sensitive regions and implementing early warning systems for potential outbreaks.
Comparatively, while excavation and climate change are external triggers, they share a common mechanism: disrupting the stable environment that keeps spores dormant. Excavation is immediate and localized, whereas climate change is gradual and widespread. Both, however, underscore the need for proactive measures. For excavation, this includes land-use planning and public health protocols. For climate change, it involves global efforts to reduce greenhouse gas emissions and regional strategies to adapt to changing environmental conditions.
In conclusion, reactivation triggers like excavation and climate change are not inevitable threats but manageable risks. By understanding how these disturbances awaken dormant anthrax spores, we can implement targeted interventions to protect public health. Whether through careful land management or climate resilience strategies, the key lies in anticipating and mitigating these triggers before they lead to reactivation.
Do HEPA Filters Effectively Remove Mold Spores from Indoor Air?
You may want to see also
Frequently asked questions
Yes, anthrax spores are highly resilient and can remain dormant in soil or other environments for decades to centuries under favorable conditions.
Anthrax spores can survive for extended periods in cool, dry, and oxygen-poor environments, such as in soil, where they are protected from heat, light, and moisture.
Yes, if dormant spores are inhaled, ingested, or come into contact with a wound, they can become active and cause anthrax infection, even after many years of dormancy.
Spores can be reactivated when they enter a host (human or animal) and encounter favorable conditions, such as warmth, moisture, and nutrients, which trigger them to revert to their active bacterial form.
Yes, there have been cases, such as the 2001 anthrax attacks in the U.S. and historical outbreaks in animals, where spores from decades or even centuries ago caused infections when disturbed or reintroduced into susceptible populations.